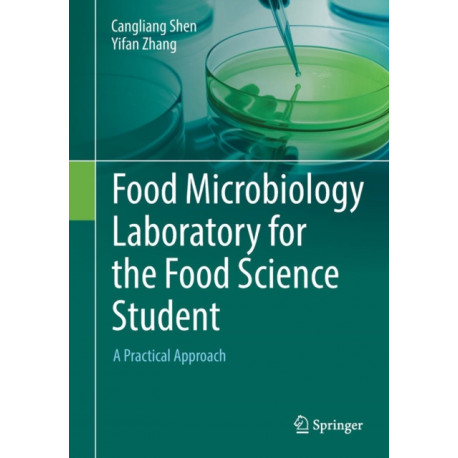
Food Microbiology Laboratory for the Food Science Student: A Practical Approach

Kurv
Vare
varer
(tom)
Ingen varer
Fastlægges senere
Forsendelse
0,- kr
I alt
Food Microbiology Laboratory for the Food Science Student: A Practical Approach
(Bog, Paperback / softback, Engelsk)
Beskrivelse
This book is designed to give students an understanding of the role of microorganisms in food processing and preservation;
Læsernes anmeldelser (0)
Alle detaljer
| Forlag | Springer International Publishing AG |
| Forfattere | Cangliang Shen, Yifan Zhang |
| Type | Bog |
| Format | Paperback / softback |
| Sprog | Engelsk |
| Udgave | 1st ed. 2017 |
| Udgivelsesdato | 24-08-2017 |
| Første udgivelsesår | 2017 |
| Illustrationer | 40 Illustrations, color; 2 Illustrations, black and white; XI, 103 p. 42 illus., 40 illus. in color. |
| Originalsprog | Switzerland |
| Sideantal | 103 |
| Indbinding | Paperback / softback |
| Forlag | Springer International Publishing AG |
| Sideoplysninger | 103 pages, 40 Illustrations, color; 2 Illustrations, black and white; XI, 103 p. 42 illus., 40 illus |
| Mål | 180 x 254 x 9 |
| ISBN-13 / EAN-13 | 9783319583709 |


